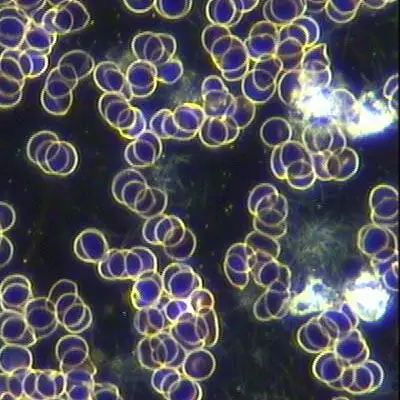

In light of Shilajit's tremendous medicinal potential, it would not be an exaggeration to say that it can be a panacea for all human ailments and Nature's wonderful gift to mankind. PubMed Study PCM2876922 ⇒COLORADO SHILAJIT INTRODUCTORY VIDEO⇒
LIVE BLOOD REVIEW OF COLORADO SHILAJIT USER⇒
COLORADO SHILAJIT RECON TRIP⇒
Colorado Shilajit Company is the first provider of USA harvested, purified, and packaged Shilajit. No other provider can claim absolute Chain of Quality Control. Why is that important?⇒
Oxygen – It’s THE BIG DEAL

The lack of cellular oxygen is the single greatest cause of dis-ease among us mortals. From cancers to dementia to chronic fatigue, cellular hypoxia is generally an aspect of all dis-ease. Always the Good Mother, Earth gives us Shilajit, a supremely ionic adaptogenic able to mitigate cellular hypoxia and the host of issues caused by the lack of cellular oxygen and carbon dioxide imbalance. Modern studies list almost innumerable benefits to the daily inclusion of Shilajit in the diet as does benefits told to us from cultures from India to Europe beginning thousands of years ago; yes, many of Shilajit’s benefits were cataloged over 4000 thousands years ago.
Continue⇒
The Power of Sound
Everything we humans can see, touch and sense vibrates. Each major organ, bones, skin and body part vibrates at a specific frequency. In fact, the very state of our wellness is directly connected to how near or far we are from our center of optimal frequency. Optimal frequency, combined with cells that are fully charged (ionically), can heal ailments, defend against attacks to our vitality and make us feel better than we ever thought possible. No matter your state of current health, consider our resonance infused product Vibrato – Pitch Perfect Health. Hand tuned by our resident Master of Sonic Healing utilizing pure tone, analog tuning in 432Hz scale with five different frequencies that precisely target specific organs and body areas. Buy More here⇒
Body Electric – Ionic Recharge
We humans are electric beings. Every aspect of our health (and ill-health) is directly influenced by whether or not our body is maximally charged to our ionic potential. In recent testing, purified Colorado Shilajit has shown that it has the highest levels of available ions of any known, unadulterated natural substance tested to date.
One does not have to reach far to understand why Shilajit may be the penultimate substance in advancing ones health to optimal levels – Shilajit’s known adaptogenic abilities can not only bring balance to the natural state, it can recharge the body to an optimal energetic state. More here⇒
Darkfield Microscopy Shilajit Blood Study
Pioneering research? Colorado Shilajit Company, along with other contributors have partnered to conduct darkfield human blood microscopy studies on the effects of Colorado Shilajit use. The study is currently active, with patients undergoing baseline testing and post Shilajit intake testing. We are already seeing some exciting, differentiating results suggesting that the data will at the least, point to new information on the direct effects of Shilajit in blood as well as collecting and cataloging visual data for diagnostic use.
Sign up for infrequent, shareworthy information and updates.
And receive a personal discount code for you next purchase

